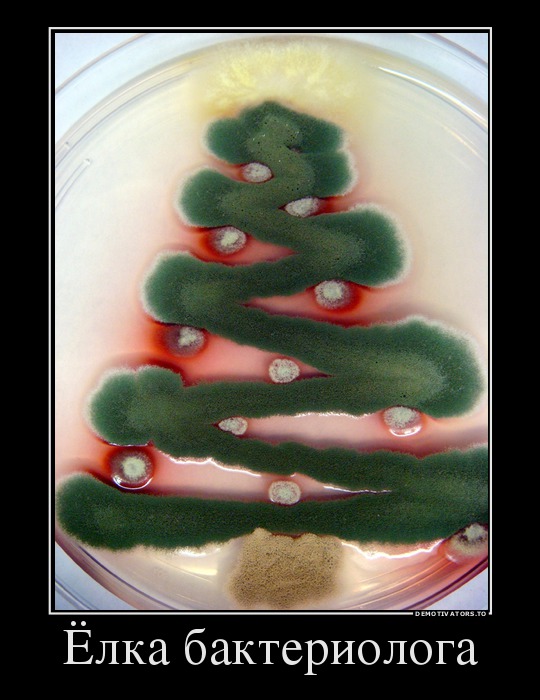

ODvinsk » Облако тегов » елка
Когда елка наряжена
Автор: demotivators.ru от 26-12-2016, 18:39, посмотрело: 3
Категория: Демотиваторы
Рижская ёлка попала в Книгу Рекордов (6 фото + видео)
Автор: от 9-12-2016, 10:39, посмотрело: 1
0
Неожиданный и интересный подарок жителям Риги решили сделать специалисты латвийской IT-компании Scandiweb, чью инициативу поддержал мер города Нил Ушаков. В назначенный день и час на Ратушной площади при многочисленных зрителях и представителях Книги рекордов Гиннеса инициаторы зажгли Рождественскую елку, воспользовавшись самой большой в мире машиной Руба Голдберга. Возможно, это был самый сложный способ зажечь праздничные огни с помощью цепной реакции, которая состояла из 412 отдельных элементов. Но эксперимент удался, а новый рекорд в этой категории зафиксировала представитель компании Guiness World Records из Германии Сейда Субаци-Гемици.
Неожиданный и интересный подарок жителям Риги решили сделать специалисты латвийской IT-компании Scandiweb, чью инициативу поддержал мер города Нил Ушаков. В назначенный день и час на Ратушной площади при многочисленных зрителях и представителях Книги рекордов Гиннеса инициаторы зажгли Рождественскую елку, воспользовавшись самой большой в мире машиной Руба Голдберга. Возможно, это был самый сложный способ зажечь праздничные огни с помощью цепной реакции, которая состояла из 412 отдельных элементов. Но эксперимент удался, а новый рекорд в этой категории зафиксировала представитель компании Guiness World Records из Германии Сейда Субаци-Гемици.
Категория: Железо
Какой год, такая и ёлка
Автор: demotivators.ru от 31-12-2015, 12:29, посмотрело: 3
Категория: Демотиваторы
Новогодняя ёлка из пивных банок (12 фото)
Автор: doseng.org от 28-11-2011, 22:13, посмотрело: 4
Категория: Фото Приколы